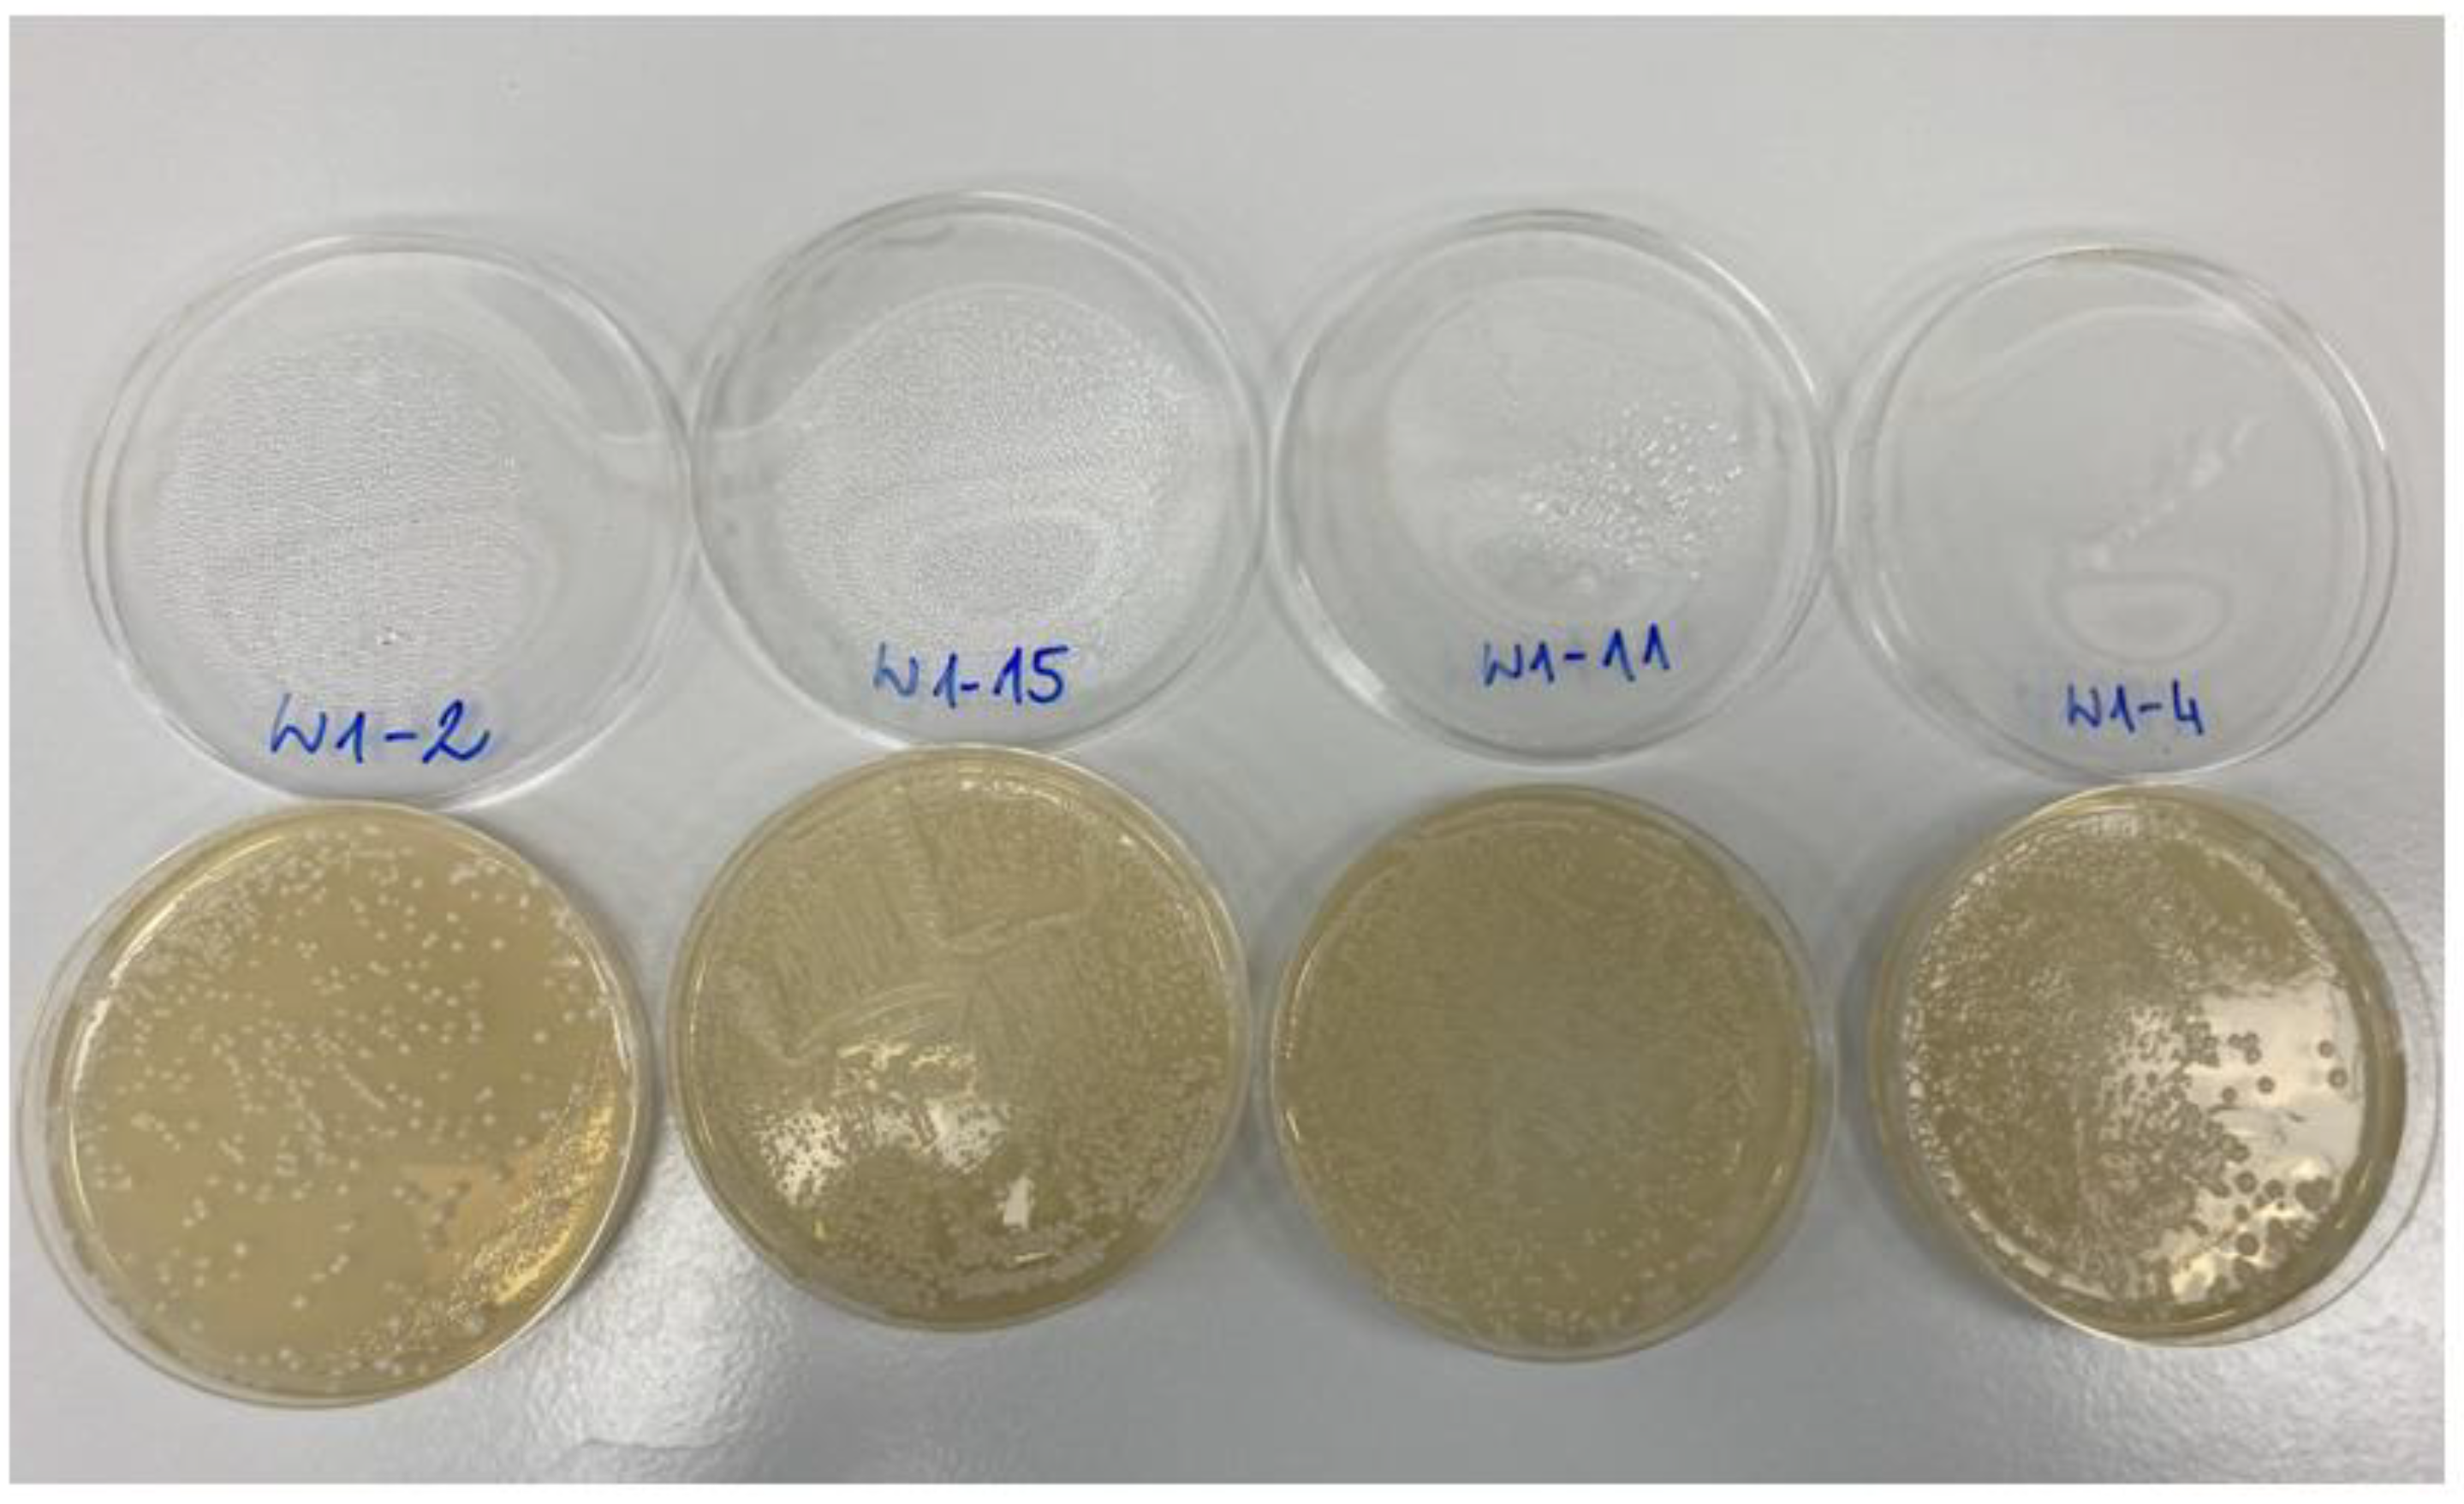
Molecules 27 07910 g001 Molecules 27 07910 g001

Effect of Hop Varieties and Forms in the Hopping Process on Non-Alcoholic Beer Quality
Abstract
1. Introduction
2. Results and Discussion
2.1. Analysis of Basic Physicochemical Parameters
2.2. Assay of Hop-Derived Volatile Compounds
2.3. Microbial Contamination Testing
2.4. Quantitative, Qualitative, and Sensory Analysis of Volatile Compounds Indicative of Microbiological/Storage Defects
3. Materials and Methods
3.1. Plant and Biological Material
3.2. Wort Preparation (Pre-Fermentation)
3.3. Pre-Fermentation Yeast Culturing
3.4. Fermentation of Wort
3.5. Analysis of Basic Physicochemical Parameters
3.6. Assay of Hop-Derived Volatile Compounds
3.7. Sensory Evaluation
3.8. Microbial Contamination Testing
3.9. Statistical Analysis
4. Conclusions
Author Contributions
Funding
Institutional Review Board Statement
Informed Consent Statement
Data Availability Statement
Conflicts of Interest
Sample Availability
References
- Tembrock, L.R.; McAleer, J.M.; Gilligan, T.M. A revision of native North American Humulus (Cannabaceae). J. Bot. Res. Inst. Tex. 2016, 10, 11–30. [Google Scholar]
- Mikyška, A.; Jurková, M.; Horák, T.; Slabý, M. Study of the influence of hop polyphenols on the sensory stability of lager beer. Eur. Food Res. Technol. 2022, 248, 533–542. [Google Scholar] [CrossRef]
- Matsche, B.; Insa, A.M.; Wiesen, E.; Schönberger, C.; Krottenthaler, M. The influence of yeast strains and hop varieties on the aroma of beer. Brew. Sci. 2018, 71, 31. [Google Scholar]
- Stanius, Ž.; Dūdėnas, M.; Kaškonienė, V.; Stankevičius, M.; Skrzydlewska, E.; Drevinskas, T.; Ragažinskiene, O.; Obelevičius, K.; Maruška, A. Analysis of the Leaves and Cones of Lithuanian Hops (Humulus lupulus L.) Varieties by Chromatographic and Spectrophotometric Methods. Molecules 2022, 27, 2705. [Google Scholar] [CrossRef]
- Stokholm, A.; Van Simaeys, K.; Gallagher, A.; Weaver, G.; Shellhammer, T.H. Investigating the Effect of Farm Management, Soil, and Climate on Hop Diastatic Potential. J. Am. Soc. Brew. Chem. 2021, 80, 389–400. [Google Scholar] [CrossRef]
- Dušek, M.; Vostřel, J.; Kalachová, K.; Jandovská, V. Seasonal and geographical variations in insecticide and miticide residues in hop samples produced across three hop-growing regions in the Czech Republic during the years 2018–2020. Food Addit. Contam. Part A 2022, 39, 1109–1122. [Google Scholar] [CrossRef]
- Kunze, W. Technology Brewing & Malting, 6th ed.; Versuchs- und Lehranstalt für Brauerei in Berlin: Berlin, Germany, 2016; pp. 1–948. [Google Scholar]
- Matukas, M.; Starkute, V.; Zokaityte, E.; Zokaityte, G.; Klupsaite, D.; Mockus, E.; Rocha, J.M.; Ruibys, R.; Bartkiene, E. Effect of different yeast strains on biogenic amines, volatile compounds and sensory profile of beer. Foods 2022, 11, 2317–2337. [Google Scholar] [CrossRef]
- Vaštík, P.; Rosenbergová, Z.; Furdíková, K.; Klempová, T.; Šišmiš, M.; Šmogrovičová, D. Potential of non-Saccharomyces yeast to produce non-alcoholic beer. FEMS Yeast Res. 2022, 22, foac039. [Google Scholar] [CrossRef]
- Bellut, K.; Arendt, E.K. Chance and challenge: Non-saccharomyces yeasts in nonalcoholic and low alcohol beer brewing–A review. J. Am. Soc. Brew. Chem. 2019, 77, 77–91. [Google Scholar] [CrossRef]
- Research and Markets. Non-Alcoholic Beer Global Market Report 2021. Available online: https://www.researchandmarkets.com/reports/5437926/ (accessed on 5 July 2022).
- Adamenko, K.; Kawa-Rygielska, J.; Kucharska, A.Z. Characteristics of Cornelian cherry sour non-alcoholic beers brewed with the special yeast Saccharomycodes ludwigii. Food Chem. 2020, 312, 125968. [Google Scholar] [CrossRef]
- Müller, M.; Gastl, M.; Becker, T. Key constituents, flavour profiles and specific sensory evaluation of wheat style non-alcoholic beers depending on their production method. J. Inst. Brew. 2021, 127, 262–272. [Google Scholar] [CrossRef]
- Moss, R.; Barker, S.; McSweeney, M.B. An analysis of the sensory properties, emotional responses and social settings associated with non-alcoholic beer. Food Qual. Prefer. 2022, 98, 104456. [Google Scholar] [CrossRef]
- Leonardi, M.; Skomra, U.; Agacka, M.; Stochmal, A.; Ambryszewska, K.E.; Oleszek, W.; Flamini, G.; Pistelli, L. Characterisation of four popular Polish hop cultivars. Int. J. Food Sci. Technol. 2013, 48, 1770–1774. [Google Scholar] [CrossRef]
- Duarte, L.M.; Aredes, R.S.; Amorim, T.L.; de Carvalho Marques, F.F.; de Oliveira, M.A.L. Determination of α-and β-acids in hops by liquid chromatography or electromigration techniques: A critical review. Food Chem. 2022, 397, 133671. [Google Scholar] [CrossRef]
- Pistelli, L.; Ferri, B.; Cioni, P.L.; Koziara, M.; Agacka, M.; Skomra, U. Aroma profile and bitter acid characterization of hop cones (Humulus lupulus L.) of five healthy and infected Polish cultivars. Ind. Crops Prod. 2018, 124, 653–662. [Google Scholar] [CrossRef]
- Sawicka, B.; Śpiewak, M.; Kiełtyka-Dadasiewicz, A.; Skiba, D.; Bienia, B.; Krochmal-Marczak, B.; Pszczółkowski, P. Assessment of the Suitability of Aromatic and High-Bitter Hop Varieties (Humulus lupulus L.) for Beer Production in the Conditions of the Małopolska Vistula Gorge Region. Fermentation 2021, 7, 104–133. [Google Scholar] [CrossRef]
- Rošul, M.; Mandić, A.; Mišan, A.; Ðerić, N.; Pejin, J. Review of trends in formulation of functional beer. Food Feed Res. 2019, 46, 23–35. [Google Scholar] [CrossRef]
- BJCP. Style Guidelines. Available online: https://www.bjcp.org/style/2015/12/12C/english-ipa/ (accessed on 10 October 2022).
- Higgins, M.J.; Bakke, A.J.; Hayes, J.E. Personality traits and bitterness perception influence the liking and intake of pale ale style beers. Food Qual. Prefer. 2020, 86, 103994. [Google Scholar] [CrossRef]
- Carvalho, F.R.; Moors, P.; Wagemans, J.; Spence, C. The influence of color on the consumer’s experience of beer. Front. Psychol. 2017, 8, 2205. [Google Scholar] [CrossRef]
- Salanță, L.C.; Coldea, T.E.; Ignat, M.V.; Pop, C.R.; Tofană, M.; Mudura, E.; Borsa, A.; Pasqualone, A.; Zhao, H. Non-alcoholic and craft beer production and challenges. Processes 2020, 8, 1382. [Google Scholar] [CrossRef]
- Mortazavian, A.M.; Razavi, S.H.; Mousavi, S.M.; Malganji, S.; Sohrabvandi, S. The effect of Saccharomyces strain and fermentation conditions on quality prameters of non-alcoholic beer. Arch. Adv. Biosci. 2014, 5, 109–114. [Google Scholar]
- Methner, Y.; Dancker, P.; Maier, R.; Latorre, M.; Hutzler, M.; Zarnkow, M.; Steinhaus, M.; Libkind, D.; Frank, S.; Jacob, F. Influence of Varying Fermentation Parameters of the Yeast Strain Cyberlindnera saturnus on the Concentrations of Selected Flavor Components in Non-Alcoholic Beer Focusing on (E)-β-Damascenone. Foods 2022, 11, 1038–1062. [Google Scholar] [CrossRef] [PubMed]
- Nikulin, J.; Aisala, H.; Gibson, B. Production of non-alcoholic beer via cold contact fermentation with Torulaspora delbrueckii. J. Inst. Brew. 2022, 128, 28–35. [Google Scholar] [CrossRef]
- De Francesco, G.; Sannino, C.; Sileoni, V.; Marconi, O.; Filippucci, S.; Tasselli, G.; Turchetti, B. Mrakia gelida in brewing process: An innovative production of low alcohol beer using a psychrophilic yeast strain. Food Microbiol. 2018, 76, 354–362. [Google Scholar] [CrossRef] [PubMed]
- Bellut, K.; Michel, M.; Zarnkow, M.; Hutzler, M.; Jacob, F.; Atzler, J.J.; Hoehnel, A.; Lynch, K.M.; Arendt, E.K. Screening and application of Cyberlindnera yeasts to produce a fruity, non-alcoholic beer. Fermentation 2019, 5, 103. [Google Scholar] [CrossRef]
- Koren, D.; Hegyesné Vecseri, B.; Kun-Farkas, G.; Urbin, A.; Nyitrai, A.; Sipos, L. How to objectively determine the color of beer? J. Food Sci. Technol. 2020, 57, 1183–1189. [Google Scholar] [CrossRef]
- Lasanta, C.; Durán-Guerrero, E.; Díaz, A.B.; Castro, R. Influence of fermentation temperature and yeast type on the chemical and sensory profile of handcrafted beers. J. Sci. Food Agric. 2021, 101, 1174–1181. [Google Scholar] [CrossRef]
- Kolpin, K.M.; Thomas, H.S. The human bitterness detection threshold of iso-α-acids and tetrahydro-iso-α-acids in lager beer. J. Am. Soc. Brew. Chem. 2009, 67, 200–205. [Google Scholar] [CrossRef]
- Peces-Pérez, R.; Vaquero, C.; Callejo, M.J.; Morata, A. Biomodulation of Physicochemical Parameters, Aromas, and Sensory Profile of Craft Beers by Using Non-Saccharomyces Yeasts. ACS Omega 2022, 7, 17822–17840. [Google Scholar] [CrossRef]
- Bamforth, C.W. Beer, carbohydrates and diet. J. Inst. Brew. 2005, 111, 259–264. [Google Scholar] [CrossRef]
- Romeo, J.; Gonzalez-Gross, M.; Wärnberg, J.; Diaz, L.E.; Marcos, A. Does beer have an impact weight gain? Effects of moderate beer consumption on body composition. Nutr. Hosp. 2007, 22, 223–228. [Google Scholar] [PubMed]
- Brendel, S.; Hofmann, T.; Granvogl, M. Characterization of key aroma compounds in pellets of different hop varieties (Humulus lupulus L.) by means of the sensomics approach. J. Agric. Food Chem. 2019, 67, 12044–12053. [Google Scholar] [CrossRef] [PubMed]
- Su, X.; Hurley, K.; Xu, Z.; Xu, Y.; Rutto, L.; O’Keefe, S.; Scoggins, H.; Yin, Y. Performance of alternative drying techniques on hop (Humulus lupulus L.) aroma quality: An HS-SPME-GC-MS-O and chemometrics combined approach. Food Chem. 2022, 381, 132289. [Google Scholar] [CrossRef] [PubMed]
- Michiu, D.; Socaci, S.A.; Jimborean, M.A.; Mudura, E.; Fărcaş, A.C.; Biriş-Dorhoi, S.E.; Tofană, M. Determination of volatile markers from magnum hops in beer by in-tube extraction—Gas chromatography—Mass spectrometry. Anal. Lett. 2018, 51, 2967–2980. [Google Scholar] [CrossRef]
- Larroy, C.; Fernández, M.R.; González, E.; Parés, X.; Biosca, J.A. Characterization of the Saccharomyces cerevisiae YMR318C (ADH6) gene product as a broad specificity NADPH-dependent alcohol dehydrogenase: Relevance in aldehyde reduction. Biochem. J. 2002, 361, 163–172. [Google Scholar] [CrossRef]
- Larroy, C.; Parés, X.; Biosca, J.A. Characterization of a Saccharomyces cerevisiae NADP (H)-dependent alcohol dehydrogenase (ADHVII), a member of the cinnamyl alcohol dehydrogenase family. Eur. J. Biochem. 2002, 269, 5738–5745. [Google Scholar] [CrossRef] [PubMed]
- Buchhaupt, M.; Guder, J.C.; Etschmann, M.M.W.; Schrader, J. Synthesis of green note aroma compounds by biotransformation of fatty acids using yeast cells coexpressing lipoxygenase and hydroperoxide lyase. Appl. Microbiol. Biotechnol. 2012, 93, 159–168. [Google Scholar] [CrossRef]
- Liu, P.T.; Duan, C.Q.; Yan, G.L. Comparing the effects of different unsaturated fatty acids on fermentation performance of Saccharomyces cerevisiae and aroma compounds during red wine fermentation. Molecules 2019, 24, 538. [Google Scholar] [CrossRef]
- Raut, S.; von Gersdorff, G.J.; Münsterer, J.; Kammhuber, K.; Hensel, O.; Sturm, B. Influence of pre-drying storage time on essential oil components in dried hops (Humulus lupulus L.). J. Sci. Food Agric. 2021, 101, 2247–2255. [Google Scholar] [CrossRef]
- Adadi, P.; Harris, A.; Bremer, P.; Silcock, P.; Ganley, A.R.; Jeffs, A.G.; Eyres, G.T. The effect of sound frequency and intensity on yeast growth, fermentation performance and volatile composition of beer. Molecules 2021, 26, 7239. [Google Scholar] [CrossRef]
- Holt, S.; Miks, M.H.; de Carvalho, B.T.; Foulquie-Moreno, M.R.; Thevelein, J.M. The molecular biology of fruity and floral aromas in beer and other alcoholic beverages. FEMS Microbiol. Rev. 2019, 43, 193–222. [Google Scholar] [CrossRef] [PubMed]
- Sun, S.; Wang, X.; Yuan, A.; Liu, J.; Li, Z.; Xie, D.; Zhang, H.; Luo, W.; Xu, H.; Liu, J.; et al. Chemical constituents and bioactivities of hops (Humulus lupulus L.) and their effects on beer-related microorganisms. Food Energy Secur. 2022, 11, e367. [Google Scholar] [CrossRef]
- Krogerus, K.; Gibson, B.R. 125th anniversary review: Diacetyl and its control during brewery fermentation. J. Inst. Brew. 2013, 119, 86–97. [Google Scholar]
- Barnes, T. The Complete Beer Fault Guide v. 1.4. 2011. Available online: https://londonamateurbrewers.co.uk/wp-content/uploads/2015/05/Complete_Beer_Fault_Guide.pdf (accessed on 15 September 2022).
- Pires, E.J.; Teixeira, J.A.; Brányik, T.; Vicente, A.A. Yeast: The soul of beer’s aroma—A review of flavour-active esters and higher alcohols produced by the brewing yeast. Appl. Microbiol. Biotechnol. 2014, 98, 1937–1949. [Google Scholar] [CrossRef] [PubMed]
- Kemp, S.E.; Hollowood, T.; Hort, J. Sensory Evaluation: A Practical Handbook; John Wiley & Sons: Chichester, UK, 2011; pp. 1–208. [Google Scholar]
- Kłosowski, G.; Mikulski, D. The effect of raw material contamination with mycotoxins on the composition of alcoholic fermentation volatile by-products in raw spirits. Bioresour. Technol. 2010, 101, 9723–9727. [Google Scholar] [CrossRef] [PubMed]
| No. | Beer | Alcohol [%v/v] | Ew [%w/w] | Er [%w/w] | RDF [%] | Kcal/100 mL | Color [EBC] | pH |
|---|---|---|---|---|---|---|---|---|
| 1 | B0 | 0.24 ± 0.0 d1 | 7.16 ± 0.13 efg | 6.78 ± 0.09 efg | 5.44 ± 0.48 c | 25.68 ± 0.49 def | 14.59 ± 0.88 f | 5.07 ± 0.01 a |
| 2 | AE40 | 0.33 ± 0.04 bcd | 7.23 ± 0.07 efg | 6.73 ± 0.12 efg | 7.03 ± 0.94 abc | 25.93 ± 0.25 def | 22.25 ± 0.33 e | 4.84 ± 0.02 ef |
| 3 | AE60 | 0.34 ± 0.06 bcd | 7.50 ± 0.32 cde | 6.99 ± 0.23 cde | 7.10 ± 1.00 abc | 26.94 ± 1.19 cde | 22.87 ± 1.18 de | 4.82 ± 0.00 f |
| 4 | AP40 | 0.33 ± 0.03 bcd | 7.09 ± 0.34 efg | 6.59 ± 0.28 efg | 7.39 ± 0.43 a | 25.42 ± 1.24 def | 24.17 ± 1.35 cde | 4.89 ± 0.02 def |
| 5 | AP60 | 0.33 ± 0.02 bcd | 6.76 ± 0.18 fg | 6.24 ± 0.18 fg | 7.74 ± 0.58 ab | 24.13 ± 0.66 ef | 28.21 ± 0.64 bc | 4.96 ± 0.03 bc |
| 6 | AC40 | 0.46 ± 0.02 a | 8.40 ± 0.11 ab | 7.70 ± 0.14 abc | 8.67 ± 0.47 a | 30.25 ± 0.43 ab | 28.91 ± 0.62 ab | 5.02 ± 0.02 ab |
| 7 | AC60 | 0.46 ± 0.05 a | 8.94 ± 0.43 a | 8.25 ± 0.36 a | 8.02 ± 0.41 a | 32.27 ± 1.60 a | 33.53 ± 2.29 a | 5.00 ± 0.06 b |
| 8 | ME40 | 0.33 ± 0.05 bcd | 7.27 ± 0.06 egd | 6.77 ± 0.02 efg | 7.15 ± 1.03 abc | 26.07 ± 0.22 def | 21.11 ± 2.82 e | 4.90 ± 0.03 de |
| 9 | ME60 | 0.28 ± 0.03 cd | 7.93 ± 0.37 bcd | 7.50 ± 0.33 bcd | 5.59 ± 0.27 bc | 28.52 ± 1.38 bcd | 22.57 ± 2.59 e | 4.84 ± 0.01 ef |
| 10 | MP40 | 0.34 ± 0.03 bcd | 6.62 ± 0.24 g | 6.11 ± 0.21 g | 8.04 ± 0.57 a | 23.56 ± 0.72 f | 21.69 ± 0.85 e | 4.88 ± 0.03 def |
| 11 | MP60 | 0.41 ± 0.02 ab | 8.18 ± 0.46 abc | 7.55 ± 0.43 abcd | 7.98 ± 0.19 a | 29.43 ± 1.70 abc | 29.45 ± 2.32 ab | 4.93 ± 0.02 cd |
| 12 | MC40 | 0.42 ± 0.08 ab | 8.60 ± 0.21 ab | 7.97 ± 0.11 ab | 7.63 ± 1.19 a | 30.99 ± 0.80 ab | 23.65 ± 2.21 bcd | 5.00 ± 0.03 bc |
| 13 | MC60 | 0.37 ± 0.07 abc | 7.48 ± 0.49 cde | 6.91 ± 0.38 def | 7.82 ± 1.08 a | 26.84 ± 1.82 cde | 27.55 ± 1.91 cde | 4.97 ± 0.01 bc |
| RT | 4.524 | 6.791 | 8.933 | 12.968 | 13.961 | 14.7 | 14.877 | 15.162 | |
|---|---|---|---|---|---|---|---|---|---|
| Compound | 1-Hexanol | β-Myrcene | Linalool | Trans-Geranic acid Methyl ester | Copaene | Caryophyllene | Trans-α-Bergamotene | (E)-β-Farnesene | |
| No. | Beer | μg/L | |||||||
| 1 | B0 | nd 1 | nd | nd | nd | nd | nd | nd | nd |
| 2 | AE40 | 1.78 ± 0.05 b2 | 2.17 ± 0.06 h | 0.94 ± 0.03 f | 1.19 ± 0.03 e | 0.92 ± 0.02 e | 16.37 ± 0.44 cde | 1.19 ± 0.03 ef | 1.53 ± 0.04 cd |
| 3 | AE60 | 0.93 ± 0.01 c | 6.01 ± 0.06 c | 1.46 ± 0.02 d | 2.42 ± 0.03 d | 1.24 ± 0.01 c | 25.55 ± 0.27 bc | 1.82 ± 0.02 cd | 2.51 ± 0.03 cd |
| 4 | AP40 | 0.69 ± 0.02 a | 3.50 ± 0.09 g | 2.87 ± 0.03 b | 3.57 ± 0.09 c | nd | 13.35 ± 0.35 de | 1.21 ± 0.03 ef | 13.83 ± 0.37 b |
| 5 | AP60 | 1.78 ± 0.11 b | 6.14 ± 0.02 c | 3.02 ± 0.04 a | 9.03 ± 0.44 a | 1.99 ± 0.02 b | 57.38 ± 1.66 a | 7.19 ± 0.51 a | 23.13 ± 0.06 a |
| 6 | AC40 | 0.57 ± 0.02 d | 6.08 ± 0.17 c | 1.42 ± 0.05 d | 3.62 ± 0.10 c | nd | 11.17 ± 0.31 ef | 1.28 ± 0.04 ef | 0.24 ± 0.01 d |
| 7 | AC60 | 1.22 ± 0.04 d | 9.12 ± 0.20 b | 1.73 ± 0.06 c | 4.05 ± 0.09 b | nd | 18.83 ± 0.23 cde | 3.35 ± 0.09 b | 6.71 ± 7.70 c |
| 8 | ME40 | 1.76 ± 0.03 b | 3.86 ± 0.07 f | 0.87 ± 0.07 f | 0.53 ± 0.01 f | 1.02 ± 0.02 d | 28.00 ± 0.54 bc | 1.86 ± 0.04 c | 0.24 ± 0.00 d |
| 9 | ME60 | 0.69 ± 0.01 b | 5.64 ± 0.07 d | 1.38 ± 0.08 d | 0.64 ± 0.01 f | 1.09 ± 0.01 d | 31.58 ± 0.40 b | 2.08 ± 0.03 c | 3.91 ± 0.05 cd |
| 10 | MP40 | 0.91 ± 0.03 c | 0.84 ± 0.03 i | 0.20 ± 0.09 h | nd | 1.24 ± 0.04 c | 24.30 ± 0.84 bcd | 1.06 ± 0.04 ef | 1.43 ± 0.05 cd |
| 11 | MP60 | nd | 4.65 ± 0.03 e | 1.07 ± 0.10 e | nd | 2.38 ± 0.13 a | 40.11 ± 1.39 bc | 1.51 ± 0.04 de | 1.96 ± 0.07 cd |
| 12 | MC40 | nd | 8.94 ± 0.29 b | 0.78 ± 0.11 g | 0.38 ± 0.01 f | nd | 8.55 ± 0.28 ef | 0.41 ± 0.01 g | 0.40 ± 0.08 d |
| 13 | MC60 | nd | 19.29 ± 0.34 a | 0.94 ± 0.12 f | 0.56 ± 0.01 f | 1.05 ± 0.02 d | 24.78 ± 0.44 bcd | 1.20 ± 0.02 ef | 0.94 ± 0.09 d |
| RT | 15.283 | 15.558 | 15.807 | 15.911 | 16.158 | 16.225 | 17.223 | 17.634 | |
|---|---|---|---|---|---|---|---|---|---|
| Compound | Humulene | γ-Muurolene | β-Selinene | α-Selinene | γ-Cadinene | Cadina-1(10),4-diene | Nerolidol | Humulene epoxide I | |
| No. | Beer | μg/L | |||||||
| 1 | B0 | nd 1 | nd | nd | nd | nd | nd | nd | nd |
| 2 | AE40 | 67.48 ± 1.81 e2 | 2.21 ± 0.06 de | 2.74 ± 0.07 b | 2.43 ± 0.07 cd | 1.84 ± 0.05 d | 2.68 ± 0.07 d | 2.28 ± 0.06 e | 1.86 ± 0.05 d |
| 3 | AE60 | 117.58 ± 1.23 c | 2.77 ± 0.03 c | 2.86 ± 0.03 b | 2.51 ± 0.03 bc | 2.80 ± 0.03 c | 3.75 ± 0.04 c | 2.31 ± 0.02 e | 1.84 ± 0.02 d |
| 4 | AP40 | 30.64 ± 0.81 f | 1.53 ± 0.04 g | 1.59 ± 0.04 d | 1.26 ± 0.03 g | 0.86 ± 0.02 e | 1.25 ± 0.03 e | 3.61 ± 0.10 b | nd |
| 5 | AP60 | 129.48 ± 2.86 b | 4.55 ± 0.23 a | 6.95 ± 0.27 a | 6.91 ± 0.38 a | 4.79 ± 0.32 a | 6.69 ± 0.43 a | 4.60 ± 0.10 a | 2.97 ± 0.26 c |
| 6 | AC40 | 32.35 ± 0.89 f | 0.95 ± 0.03 h | 1.33 ± 0.04 e | 1.34 ± 0.04 fg | 0.99 ± 0.03 e | 1.00 ± 0.03 e | 1.36 ± 0.04 h | 0.45 ± 0.01 h |
| 7 | AC60 | 48.13 ± 1.05 f | 2.02 ± 0.01 ef | 2.84 ± 0.11 b | 2.20 ± 0.01 de | 1.89 ± 0.07 d | 2.52 ± 0.03 d | 2.44 ± 0.18 e | 0.89 ± 0.05 g |
| 8 | ME40 | 120.80 ± 2.32 c | 2.39 ± 0.05 d | 2.36 ± 0.05 c | 2.15 ± 0.04 e | 2.76 ± 0.05 c | 3.70 ± 0.07 c | 2.44 ± 0.05 e | 2.97 ± 0.06 c |
| 9 | ME60 | 132.28 ± 1.66 b | 2.77 ± 0.33 c | 2.71 ± 0.03 b | 2.29 ± 0.03 cde | 3.01 ± 0.04 c | 3.88 ± 0.05 c | 2.98 ± 0.04 d | 3.59 ± 0.05 b |
| 10 | MP40 | 93.53 ± 3.24 d | 2.28 ± 0.08 d | 1.67 ± 0.06 d | 1.56 ± 0.05 f | 1.86 ± 0.06 d | 2.60 ± 0.09 d | 1.88 ± 0.07 f | 1.95 ± 0.07 d |
| 11 | MP60 | 169.00 ± 5.40 a | 3.49 ± 0.22 b | 2.75 ± 0.08 b | 2.73 ± 0.11 b | 3.26 ± 0.17 b | 5.47 ± 0.16 b | 3.24 ± 0.14 c | 4.03 ± 0.15 a |
| 12 | MC40 | 44.30 ± 1.45 f | 0.66 ± 0.02 i | 1.03 ± 0.03 f | 0.58 ± 0.02 h | 0.82 ± 0.03 e | 1.20 ± 0.04 e | 0.72 ± 0.02 i | 1.17 ± 0.04 f |
| 13 | MC60 | 114.86 ± 2.03 c | 1.80 ± 0.03 f | 2.20 ± 0.04 c | 1.45 ± 0.03 fg | 1.92 ± 0.03 d | 2.56 ± 0.05 d | 1.59 ± 0.03 g | 1.52 ± 0.03 e |
| Compound | 2,3-Butanedione | Trans-2-nonenal | 4-Vinyl guaiacol | Acetaldehyde | p-Menthano-8-mercapto-3-on | Octanoic acid | Isovaleric acid | 2,4,6-Trichloroanizol | 1-Propanol | 2-Methylbutanol | 3-Methylbutanol | |
|---|---|---|---|---|---|---|---|---|---|---|---|---|
| No. | Beer | mg/L | ||||||||||
| 1 | B0 | nd 1 | nd | nd | 1.84 ± 0.04 bc | nd | nd | nd | nd | 0.85 ± 0.04 h | 0.68 ± 0.04 def | 1.68 ± 0.10 cde |
| 2 | AE40 | 142.61 ± 2.60 ef2 | nd | nd | 1.54 ± 0.03 d | nd | nd | nd | nd | 0.88 ± 0.02 h | 0.68 ± 0.01 def | 1.44 ± 0.00 g |
| 3 | AE60 | 175.26 ± 11.45 c | nd | nd | 2.31 ± 0.13 a | nd | nd | nd | nd | 0.93 ± 0.01 fgh | 0.70 ± 0.01 de | 1.52 ± 0.06 fg |
| 4 | AP40 | 135.64 ± 7.89 fg | nd | nd | 1.74 ± 0.06 c | nd | nd | nd | nd | 0.91 ± 0.04 gh | 0.71 ± 0.01 d | 1.58 ± 0.04 efg |
| 5 | AP60 | 436.85 ± 25.89 a | nd | nd | 1.50 ± 0.00 d | nd | nd | nd | nd | 1.04 ± 0.02 def | 0.69 ± 0.00 def | 1.46 ± 0.04 g |
| 6 | AC40 | 116.52 ± 8.01 g | nd | nd | 1.58 ± 0.03 d | nd | nd | nd | nd | 1.18 ± 0.05 bc | 0.78 ± 0.01 c | 1.77 ± 0.02 bcd |
| 7 | AC60 | 147.83 ± 10.22 def | nd | nd | 1.12 ± 0.03 f | nd | nd | nd | nd | 1.14 ± 0.06 bcde | 0.80 ± 0.02 bc | 1.80 ± 0.03 bc |
| 8 | ME40 | 168.77 ± 9.38 cd | nd | nd | 1.54 ± 0.08 d | nd | nd | nd | nd | 0.92 ± 0.05 fgh | 0.65 ± 0.03 g | 1.55 ± 0.06 efg |
| 9 | ME60 | 270.62 ± 8.72 b | nd | nd | 2.40 ± 0.07 a | nd | nd | nd | nd | 1.10 ± 0.09 cde | 0.66 ± 0.04 fg | 1.65 ± 0.09 def |
| 10 | MP40 | 161.62 ± 5.72 cde | nd | nd | 1.25 ± 0.01 e | nd | nd | nd | nd | 1.01 ± 0.11 efg | 0.80 ± 0.04 bc | 1.68 ± 0.07 cde |
| 11 | MP60 | 287.58 ± 5.66 b | nd | nd | 1.27 ± 0.04 e | nd | nd | nd | nd | 1.17 ± 0.00 bcd | 0.81 ± 0.01 bc | 1.83 ± 0.01 b |
| 12 | MC40 | 74.59 ± 11.30 h | nd | nd | 1.90 ± 0.01 b | nd | nd | nd | nd | 1.35 ± 0.07 a | 0.92 ± 0.01 a | 2.11 ± 0.09 a |
| 13 | MC60 | 71.00 ± 13.25 h | nd | nd | 1.89 ± 0.03 b | nd | nd | nd | nd | 1.27 ± 0.07 ab | 0.84 ± 0.01 b | 1.88 ± 0.01 b |
| Compound | 2,3-Butanedione | Trans-2-nonenal | 4-Vinyl guaiacol | Acetaldehyde | p-Menthano-8-mercapto-3-on | Octanoic acid | Isovaleric acid | 2,4,6-Trichloroanizol | 1-Propanol | 2-Methylbutanol | 3-Methylbutanol | |
|---|---|---|---|---|---|---|---|---|---|---|---|---|
| No. | Beer | |||||||||||
| 1 | B0 | nd 1 | nd | nd | • | nd | nd | nd | nd | nd | nd | nd |
| 2 | AE40 | nd | nd | nd | nd | nd | nd | nd | nd | nd | nd | nd |
| 3 | AE60 | • 2 | • | nd | • | nd | nd | nd | nd | • | • | • |
| 4 | AP40 | nd | nd | nd | nd | nd | nd | nd | nd | nd | nd | nd |
| 5 | AP60 | nd | nd | • | • | nd | nd | nd | nd | • | • | • |
| 6 | AC40 | nd | • | •• | ••• | nd | nd | nd | nd | • | • | • |
| 7 | AC60 | nd | nd | nd | •• | nd | nd | nd | nd | nd | nd | nd |
| 8 | ME40 | nd | nd | •• | •• | • | nd | nd | nd | nd | nd | nd |
| 9 | ME60 | nd | nd | nd | nd | nd | nd | nd | nd | nd | nd | nd |
| 10 | MP40 | nd | nd | nd | nd | nd | nd | nd | nd | nd | nd | nd |
| 11 | MP60 | nd | nd | nd | nd | nd | nd | nd | nd | nd | nd | nd |
| 12 | MC40 | nd | nd | nd | nd | nd | nd | nd | nd | • | • | • |
| 13 | MC60 | nd | nd | •• | • | nd | nd | nd | nd | • | • | • |
Publisher’s Note: MDPI stays neutral with regard to jurisdictional claims in published maps and institutional affiliations. |
© 2022 by the authors. Licensee MDPI, Basel, Switzerland. This article is an open access article distributed under the terms and conditions of the Creative Commons Attribution (CC BY) license (https://creativecommons.org/licenses/by/4.0/).
Share and Cite
Adamenko, K.; Kawa-Rygielska, J. Effect of Hop Varieties and Forms in the Hopping Process on Non-Alcoholic Beer Quality. Molecules 2022, 27, 7910. https://doi.org/10.3390/molecules27227910
Adamenko K, Kawa-Rygielska J. Effect of Hop Varieties and Forms in the Hopping Process on Non-Alcoholic Beer Quality. Molecules. 2022; 27(22):7910. https://doi.org/10.3390/molecules27227910
Chicago/Turabian StyleAdamenko, Kinga, and Joanna Kawa-Rygielska. 2022. "Effect of Hop Varieties and Forms in the Hopping Process on Non-Alcoholic Beer Quality" Molecules 27, no. 22: 7910. https://doi.org/10.3390/molecules27227910
APA StyleAdamenko, K., & Kawa-Rygielska, J. (2022). Effect of Hop Varieties and Forms in the Hopping Process on Non-Alcoholic Beer Quality. Molecules, 27(22), 7910. https://doi.org/10.3390/molecules27227910




